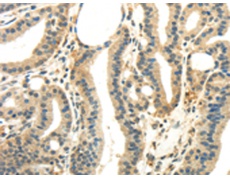
一抗

中文名稱:兔抗WNK2多克隆抗體
英文名稱: Anti-WNK2 rabbit polyclonal antibody
別 名: PRKWNK2; NY-CO-43; SDCCAG43; P/OKcl.13
相關類別: 一抗
儲 存: 冷凍(-20℃)
宿 主: Rabbit
抗 原: WNK2
反應種屬: Human, Mouse
標 記 物: Unconjugate
克隆類型: rabbit polyclonal
技術規(guī)格
|
Background: |
The protein encoded by this gene is a cytoplasmic serine-threonine kinase that belongs to the protein kinase superfamily. The protein plays an important role in the regulation of electrolyte homeostasis, cell signaling survival, and proliferation. Alternative splicing results in multiple transcript variants. |
|
Applications: |
ELISA, WB, IHC |
|
Name of antibody: |
WNK2 |
|
Immunogen: |
Synthetic peptide of humanWNK2 |
|
Full name: |
WNK lysine deficient protein kinase 2 |
|
Synonyms: |
PRKWNK2; NY-CO-43; SDCCAG43; P/OKcl.13 |
|
SwissProt: |
Q9Y3S1 |
|
ELISA Recommended dilution: |
1000-2000 |
|
IHC positive control: |
Human thyroid cancer and Human prostate cancer |
|
IHC Recommend dilution: |
25-100 |
|
WB Predicted band size: |
243 kDa |
|
WB Positive control: |
A431 and MCF7 cells |
|
WB Recommended dilution: |
200-1000 |


 購物車
購物車 幫助
幫助
 021-54845833/15800441009
021-54845833/15800441009